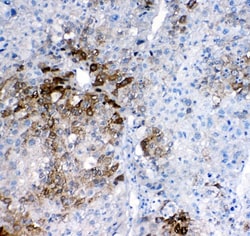

Learn More
Invitrogen™ GSTA1/A2/A3/A4/A5 Polyclonal Antibody


Rabbit Polyclonal Antibody
Supplier: Invitrogen™ PA579335
Description
Reconstitute with 0.2 mL of distilled water to yield a concentration of 500 μg/mL. Positive Control - WB: human HepG2 whole cell, human HCCT tissue, human HCCP tissue, human HUH-7 whole cell, rat liver tissue, rat RH35 whole cell, mouse liver tissue. IHC: human lung cancer tissue, human liver cancer tissue, human liver cancer tissue.
Cytosolic and membrane-bound forms of glutathione S-transferase are encoded by two distinct supergene families. These enzymes function in the detoxification of electrophilic compounds, including carcinogens, therapeutic drugs, environmental toxins and products of oxidative stress, by conjugation with glutathione. The genes encoding these enzymes are known to be highly polymorphic. These genetic variations can change an individual's susceptibility to carcinogens and toxins as well as affect the toxicity and efficacy of some drugs. At present, eight distinct classes of the soluble cytoplasmic mammalian glutathione S-transferases have been identified: alpha, kappa, mu, omega, pi, sigma, theta and zeta. This gene encodes a glutathione S-transferase belonging to the alpha class. The alpha class genes, located in a cluster mapped to chromosome 6, are the most abundantly expressed glutathione S-transferases in liver (hepatocytes) and kidney (proximal tubules). In addition to metabolizing bilirubin and certain anti-cancer drugs in the liver, the alpha class of these enzymes exhibit glutathione peroxidase activity, thereby protecting the cells from reactive oxygen species and the products of peroxidation.
Specifications
| GSTA1/A2/A3/A4/A5 | |
| Polyclonal | |
| Unconjugated | |
| Gsta4 | |
| 13-hydroperoxyoctadecadienoate peroxidase; Androst-5-ene-3,17-dione isomerase; GHS transferase; glutathione S-alkyltransferase A1; glutathione S-alkyltransferase A2; glutathione S-alkyltransferase A3; glutathione S-alkyltransferase A4; glutathione S-aralkyltransferase A2; glutathione S-aralkyltransferase A3; glutathione S-aralkyltransferase A4; glutathione S-aryltransferase A1; glutathione S-aryltransferase A2; glutathione S-aryltransferase A3; glutathione S-aryltransferase A4; glutathione S-transferase 2; glutathione S-transferase 5.7; Glutathione S-transferase A1; Glutathione S-transferase A1, N-terminally processed; Glutathione S-transferase A2; glutathione S-transferase A3; glutathione S-transferase A3 subunit; glutathione S-transferase A3-3; Glutathione S-transferase A4; glutathione S-transferase A4-4; Glutathione S-transferase A5; glutathione S-transferase A5-5; glutathione S-transferase alpha 1; glutathione S-transferase alpha 2; glutathione S-transferase alpha 3; glutathione S-transferase alpha 4; glutathione S-transferase alpha 5; glutathione S-transferase alpha-1; Glutathione S-transferase alpha-2; glutathione S-transferase alpha-3; Glutathione S-transferase alpha-4; glutathione S-transferase alpha-5; Glutathione S-transferase GT41A; glutathione S-transferase Ha subunit 1; glutathione S-transferase Ya; glutathione S-transferase Ya subunit; glutathione S-transferase Ya1; glutathione S-transferase Ya-1; Glutathione S-transferase Ya-2; Glutathione S-transferase Ya3; glutathione S-transferase Yc; Glutathione S-transferase Yc-1; glutathione S-transferase Yc1 subunit; Glutathione S-transferase Yc-2; glutathione S-transferase Yc2 subunit; glutathione S-transferase Yk; glutathione S-transferase, alpha 1 (Ya); glutathione S-transferase, alpha 2 (Yc2); glutathione S-transferase, alpha 3; glutathione S-transferase, alpha 4; glutathione transferase; glutathione transferase A4-4; glutathione transferase A5; glutathione transferase YA subunit; Glutathione-S-transferase alpha type (Ya); Glutathione-S-transferase alpha type (Yc2); glutathione-S-transferase, alpha type2; GST 1-1; GST 1a-1a; GST 1b-1b; GST 2-2; GST 5.7; GST 8-8; GST A1-1; GST A2-2; GST A3-3; GST A4-4; GST A5-5; GST AA; GST B; GST class-alpha member 1; GST class-alpha member 2; GST class-alpha member 3; GST class-alpha member 4; GST class-alpha member 5; GST HA subunit 1; GST HA subunit 2; GST K; GST Ya1; GST Ya2; GST Yc1; GST Yc2; GST Yk; GST2; Gst2-1; Gst2-2; Gst2-3; GST5.7; Gsta; Gsta1; GSTA1-1; Gsta2; GSTA2-2; GSTA3; GSTA3-3; GSTA4; GSTA4-4; Gsta5; Gstc2; Gstc-2; GST-epsilon; GST-gamma; Gstya; Gstyc; Gstyc1; Gstyc2; GTA2; GTA3; GTA4; GTH1; GTH2; Ligandin; liver GST2; mGsta4; OTTMUSG00000031890; S-(hydroxyalkyl)glutathione lyase A1; S-(hydroxyalkyl)glutathione lyase A2; S-(hydroxyalkyl)glutathione lyase A3; S-(hydroxyalkyl)glutathione lyase A4; testicular tissue protein Li 80; testis tissue sperm-binding protein Li 59n; Yc1; Yc2 | |
| Rabbit | |
| Antigen affinity chromatography | |
| RUO | |
| 100042314, 14857, 14858, 14859, 14860, 221357, 24421, 24422, 2938, 2939, 2940, 2941, 300850, 494499, 494500 | |
| -20°C | |
| Lyophilized |
| ELISA, Immunohistochemistry (Paraffin), Western Blot | |
| 500 μg/mL | |
| PBS with 5mg BSA and 0.05mg sodium azide | |
| O15217, P00502, P04903, P04904, P08263, P09210, P10648, P13745, P14942, P24472, P30115, P46418, Q16772, Q7RTV2 | |
| GSTA1, GSTA2, Gsta3, Gsta4, Gsta5 | |
| E. coli-derived human GSTA1/A2/A3/A4/A5 recombinant protein (Position: A2-F222). | |
| 100 μg | |
| Primary | |
| Human, Mouse, Rat | |
| Antibody | |
| IgG |
Safety and Handling
Your input is important to us. Please complete this form to provide feedback related to the content on this product.